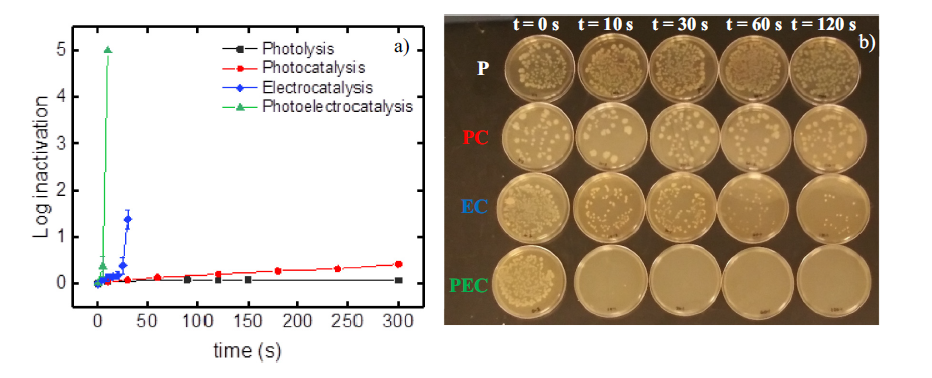

Portable point-of-use photoelectrocatalytic device provides rapid water disinfection
ABSTRACT
Portable water purification devices are needed to provide safe drinking water in rural communities, developing communities with low quality centralized water distribution, and military or recreational applications. Filtration, ultraviolet light, or chemical additives provide a spectrum of alternatives to remove pathogens from water. For the first time, we design, fabricate and demonstrate the performance of a small portable photoelectric point-of-use device, and document its performance on pathogen inactivation. The device utilizes a commercial teacup from which TiO2 nanotube photoanodes were produced in-situ and, with a small rechargeable battery powered 365 nm light emitting diode, was able to achieve 5-log inactivation of Escherichia coli in 10 s and 2.6-log of Legionella in 60 s of treatment in model water samples. Treatment of natural water achieved a 1-log bacteria inactivation after 30 s due to matrix effects. The electro-photocatalytic disinfection reactor in a kup (e-DRINK) can provide a feasible and affordable solution to ensure access to clean water. More broadly, this work demonstrates the potential for illumination to improve the efficiency of electrocatalytic surfaces.

Some Important results